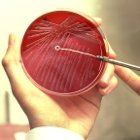

Massenvernichtungswaffen – ein politischer Begriff
Der Begriff Massenvernichtungswaffen hat eine lange, wechselhafte Geschichte. Eine allgemein anerkannte oder völkerrechtlich verbindliche Definition gibt es nicht.
Weiter ...
© picture alliance / akg-images
Der Begriff Massenvernichtungswaffen hat eine lange, wechselhafte Geschichte. Eine allgemein anerkannte oder völkerrechtlich verbindliche Definition gibt es nicht.
Weiter ...
© picture alliance / Christian Kober/robertharding
Atomwaffen (auch Kernwaffen und Nuklearwaffen genannt) sind Massenvernichtungswaffen, deren Wirkungen auf Kernspaltung oder Kernfusion beruhen.
Weiter ...
© picture-alliance / dpa/dpaweb
Für die Vereinten Nationen sind biologische Waffen „alle gezielt eingesetzten Entwicklung, Herstellung und Lagerung sind seit der internationalen Biowaffenkonvention von 1972 verboten, der Einsatz wurde schon im Genfer Protokoll von 1925 untersagt.
Weiter ...
© picture-alliance / akg-images
Chemische Waffen können als Massenvernichtungsmittel viele Tote und Verwundete fordern. Dabei sind sie relativ billig in der Herstellung. Die ersten Chemiewaffen wurden während des Ersten Weltkriegs entwickelt und eingesetzt.
Weiter ...
© picture-alliance/ dpa/dpaweb
Trägersysteme können je nach Stationierungsart in land-, luft- und seegestützte Systeme oder je nach Aufgabe in Luftabwehr-, See- oder Landzielwaffen untergliedert werden.
Weiter ...
© picture alliance / AP Photo
Seit dem 8. August 1945, dem Tag der Zerstörung Nagasakis durch die Atomwaffe „Fat Man“, ist nie wieder eine nukleare Waffe im Krieg eingesetzt worden. Dieses Tabu gilt seit mehr als 65 Jahren.
Weiter ...
© picture alliance / abaca
Mit Hilfe Frankreichs wurde 1956 ein nuklearer Forschungsreaktor in Dimona in der Negev-Wüste in Israel gebaut. Später kam eine unterirdische Wiederaufbereitungsanlage hinzu, in der Plutonium für den Bombenbau produziert wurde.
Weiter ...
© picture alliance / AP Photo
Im April 2012 wurde in die Verfassung Nordkoreas die Formulierung aufgenommen, dass das Land „im Besitz der Atomwaffe“ sei (Nordkorea bezeichnet sich offiziell als Atommacht). 2006, 2009, 2013 und 2016 hat der autoritär regierte Staat jeweils einen Atomtest durchgeführt.
Weiter ...
© picture-alliance / dpa
Atomwaffen prägen die Geschichte Europas seit fast 60 Jahren. Im März 1955 brachten die US-Streitkräfte ihre ersten atomaren Fliegerbomben in die Bundesrepublik.
Weiter ...
© picture-alliance / dpa
Die zivile und die militärische Nutzung der Kerntechnik ähneln siamesischen Zwillingen: Sie sind so eng miteinander verbunden, dass sie sich kaum voneinander trennen lassen.
Weiter ...
© picture-alliance / dpa
Unmittelbar nach den Atomwaffeneinsätzen in Hiroshima und Nagasaki begannen erste Bemühungen zur Einhegung und Eliminierung der atomaren Gefahr. Diese dauern bis heute an. Prinzipiell können entsprechende bilaterale, multilaterale und universelle Vereinbarungen zwei Ziele haben.
Weiter ...
© picture alliance / Everett Collection
Die Angst vor einer nuklearen Waffe in den Händen von Terroristen ist fast so alt wie die Atombombe selbst. Schon Anfang der 1950er Jahre warnte Robert Oppenheimer, einer der Väter der amerikanischen Nuklearwaffen, dass drei oder vier Menschen New York zerstören könnten, ...
Weiter ...
© picture-alliance / dpa
Radioaktives Material stammt aus Kernwaffen, Kraftwerken und auch Forschungsreaktoren. Unter radiologischem Material versteht man Stoffe mit eher geringer Strahlung, wie sie in der Industrie und Medizin, besonders in der Strahlentherapie, gebraucht werden.
Weiter ...
© picture-alliance / dpa
Biowaffen gelten als „exotisch“, tatsächlich sind sie aber so alt wie die Geschichte des Krieges selbst. In der Hoffnung, damit Krankheiten auszulösen, bewarfen schon die alten Römer ihre Feinde mit menschlichem Kot.
Weiter ...
© picture-alliance / dpa
Die 1971 von den Vereinten Nationen angenommene sogenannte „Biowaffenkonvention“ geht einen entscheidenden Schritt weiter als das ein halbes Jahrhundert vorher ausgehandelte Genfer Protokoll, das den Einsatz von biologischen Kampfmitteln zu unterbinden suchte.
Weiter ...
© picture-alliance / dpa
Die Generalversammlung der Vereinten Nationen nahm am 16. Dezember 1971 die sogenannte „Biowaffenkonvention“ an. Der volle Titel lautet auf Deutsch: „Konvention über das Verbot der Entwicklung, Herstellung und Lagerung bakteriologischer (biologischer) Waffen und von Toxinwaffen sowie über die Vernichtung solcher Waffen“.
Weiter ...
© picture-alliance / dpa
Kaum war die Bedrohung des Kalten Krieges vorbei, ging in der westlichen Welt die Angst um, terroristische Gruppierungen könnten sich Massenvernichtungswaffen besorgen und damit verheerende Anschläge verüben. Der Einsatz biologischer Waffen durch derartige „Superterroristen“ erschien dabei als eine ganz besonders große Gefahr.
Weiter ...
© picture alliance / Bildagentur-online/Belcher
Nach Erkenntnissen der Chemiker besteht die materielle Welt aus über 40 Millionen verschiedener Stoffe, von denen 80.000 Verbindungen auch industriell hergestellt werden. Ein Teil dieser Substanzen hat eine für den Menschen oder die Natur schädliche Wirkung.
Weiter ...
© picture alliance / ZUMAPRESS.com
Chemische Waffen zählen zu den Massenvernichtungsmitteln. Durch ihren Einsatz können und sollen eine Vielzahl von Personen bzw. Soldaten in einem mehr oder weniger großen Gebiet getötet werden.
Weiter ...
© picture alliance / AP Images
Chemiewaffen waren die ersten Massenvernichtungswaffen. Trotz zahlloser Opfer war ihr Einsatz in keinem Fall kriegsentscheidend. Wiederholt hatten die Angreifer selbst unter den Spätfolgen zu leiden, so etwa die US-Veteranen des Vietnamkrieges.
Weiter ...
© picture-alliance/dpa
Für einige ausgewählte Kartenlayer stellt das Informationsportal Krieg und Frieden die vollständigen zugrunde liegenden Datensätze in tabellarischer Form bereit.
Weiter ...
© picture-alliance/dpa
Die Informationen und Daten eines jeden Moduls werden primär in Form von aktivierbaren Kartenlayern bereitgestellt und durch Texte und Grafiken ergänzt. Die Kartenlayer sind in dem Menübaum auf der rechten Seite nach Themen und Unterthemen sortiert aufgelistet.
Weiter ...
© picture-alliance/dpa
In den Länderportäts werden die Daten und Informationen länderweise zusammengeführt und tabellarisch aufbereitet, die in den Modulen für die Darstellung in Karten und Abbildungen genutzt wurden.
Weiter ...